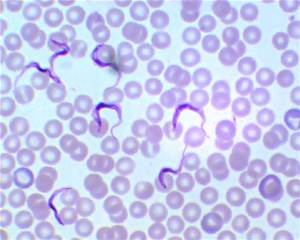
knowt flashcard image
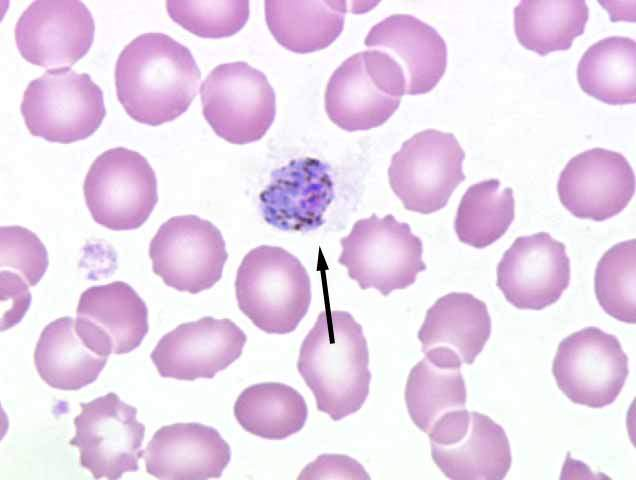
knowt flashcard image

1/23
Looks like no tags are added yet.
Name | Mastery | Learn | Test | Matching | Spaced |
|---|
No study sessions yet.
giardia lamblia trophozoite

giardia lamblia cyst

entamoeba histolytica cyst

entamoeba histolytica trophozoite

balantidium coli trophozoite

balantidium coli cyst

Trypanasoma gambiense trophozoite
plasmodium vivax merozoite
plasmodium vivax signet ring

sarcodina
entomoeba histolytica class
mastigophora
giardia lamblia class
cilliophora
balantidium coli class
amebic dysentary
entamoeba histolytica disease
dysentery
giardia lamblia disease
dysentery
balantidium coli disease
chagas disease
Trypanosoma cruzi disease
african sleeping sicknes
Trypanasoma brucei disease
malaria
plasmodium vivax disease
fecal oral food and water
balantidium coli vector
contaminated water
entamoeba histolytica vector
contaminated water, kids in day care, homoexual men
giardia lamblia vector
triatoma / reduviid bug / kissing bug
trypanasoma cruzi vector
tse tse fly / glossina
trypanasoma brucei vector
female anopheles mosquito
plasmodium vivax vector